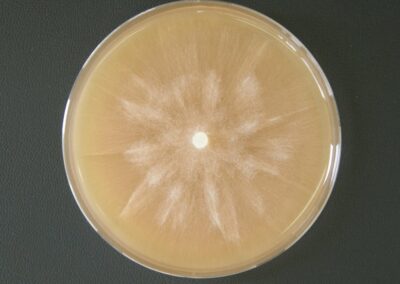

Česká sbírka fytopatogenních oomycetů
Sbírka byla založena v r. 2005 v rámci výzkumného záměru, od r. 2012 je součástí Národního programu konzervace a využívání genetických zdrojů mikroorganismů (NPGZM). Sbírka slouží k uchování genofondu významných fytopatogenních a dalších oomycetů ČR a k výzkumným a dalším účelům (testy patogenity a rezistence, testování a vývoj metod ochrany, srovnávací materiál pro SRS a jiné instituce, taxonomie, studijní účely, aj.).
V současné době je ve veřejné části sbírky uloženo cca 583 kmenů 54 taxonů oomycetů náležejících do rodů Phytophthora (30 taxonů) a Pythium (24 taxonů). V pracovní části sbírky je uloženo cca 430 dalších izolátů. Izoláty byly získány z mnoha desítek různých taxonů hostitelů – zejména lesních, okrasných a ovocných dřevin a z dalších hostitelů a z nejrůznějších typů porostů a výsadeb v rámci celé ČR (městské parky, soukromé zahrady, břehové a lesní porosty, okrasné školky, sady, zahradnické prodejny). Personál sbírky tvoří Marcela Mrázková (kurátor), Markéta Hrabětová (molekulární determinace) a Liliya Fedusiv (technik).
Autoři sbírky
Přehled uložených taxonů k 31. 1. 2021
Phytophthora
1. Phytophthora P. ×alni
2. Phytophthora bilorbang
3. Phytophthora cactorum
4. Phytophthora cambivora
5. Phytophthora cinnamomi
6. Phytophthora citrophthora
7. Phytophthora cryptogea
8. Phytophthora gallica
9. Phytophthora gonapodyides
10. Phytophthora gregata
11. Phytophthora hedraiandra
12. Phytophthora chlamydospora × amnicola
13. Phytophthora inundata
14. Phytophthora lacustris
15. Phytophthora megasperma
16. Phytophthora multivora
17. Phytophthora nicotianae
18. Phytophthora occultans
19. Phytophthora palmivora
20. Phytophthora plurivora
21. Phytophthora polonica
22. Phytophthora pseudosyringa
23. Phytophthora ramorum
24. Phytophthora rosacearum
25. Phytophthora rubi
26. Phytophthora sansomeana
27. Phytophthora syringae
28. Phytophthora taxon Raspberry
29. Phytophthora taxon Walnut
30. Phytophthora uniformis
Pythium
1. Pythium anandrum
2. Pythium citrinum
3. Pythium conidiophorum
4. Pythium cylindrosporum
5. Pythium dimorphum
6. Pythium dissimile
7. Pythium emineosum
8. Pythium folliculosum
9. Pythium helicandrum
10. Pythium helicoides
11. Pythium heterothallicum
12. Pythium chamaihyphon
13. Pythium intermedium
14. Pythium irregulare
15. Pythium litorale
16. Pythium macrosporum
17. Pythium mamillatum
18. Pythium mercuriale
19. Pythium oopapillum
20. Pythium pachycaule
21. Pythium spiculum
22. Pythium ultimum
23. Pythium undulatum
24. Pythium vexans
Kompletní katalog – fytopatogenní oomycety, 31. 1. 2021, VÚKOZ
Objednávkový formulář
Izoláty lze také vyhledat v průběžně aktualizované databázi sbírek NPGZM.